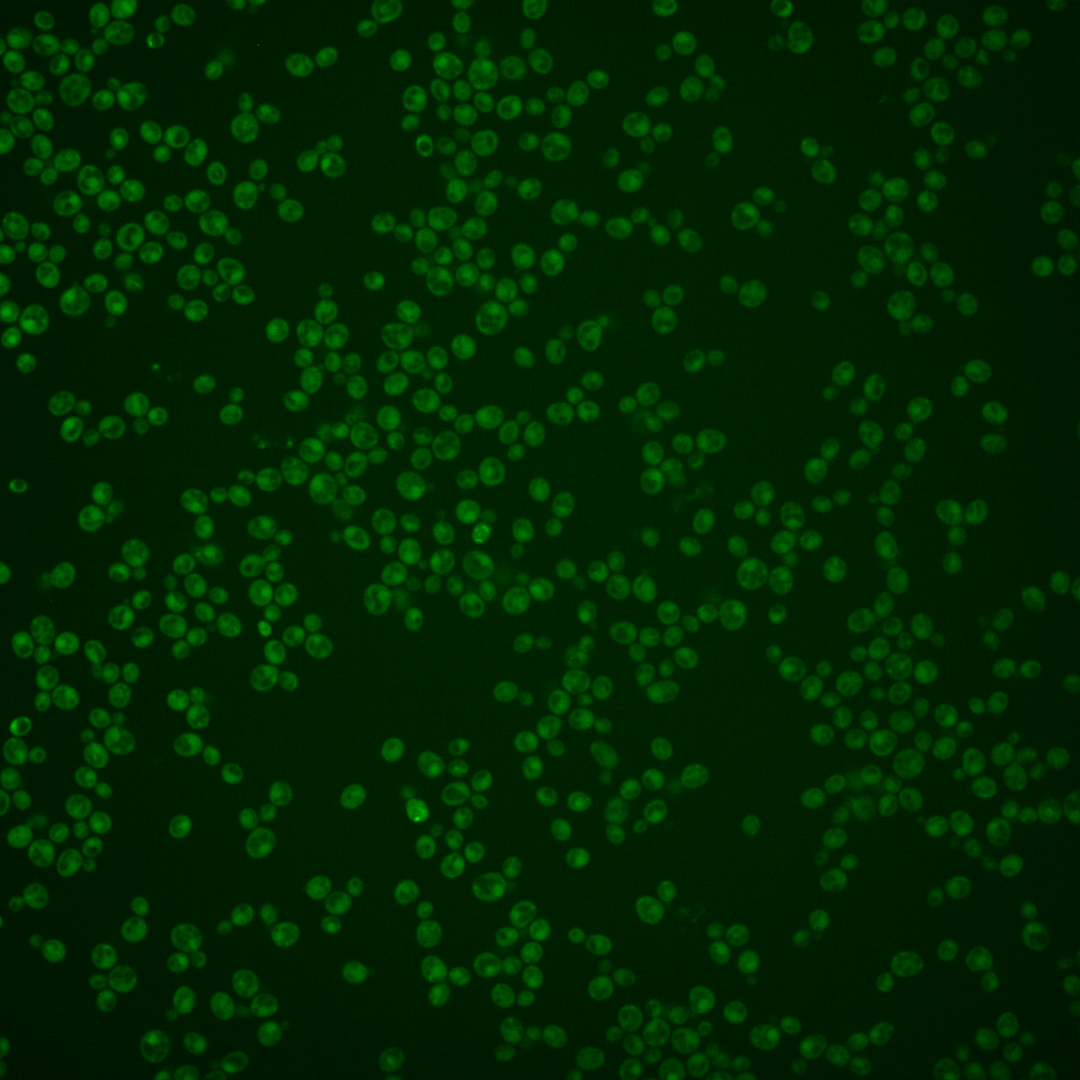
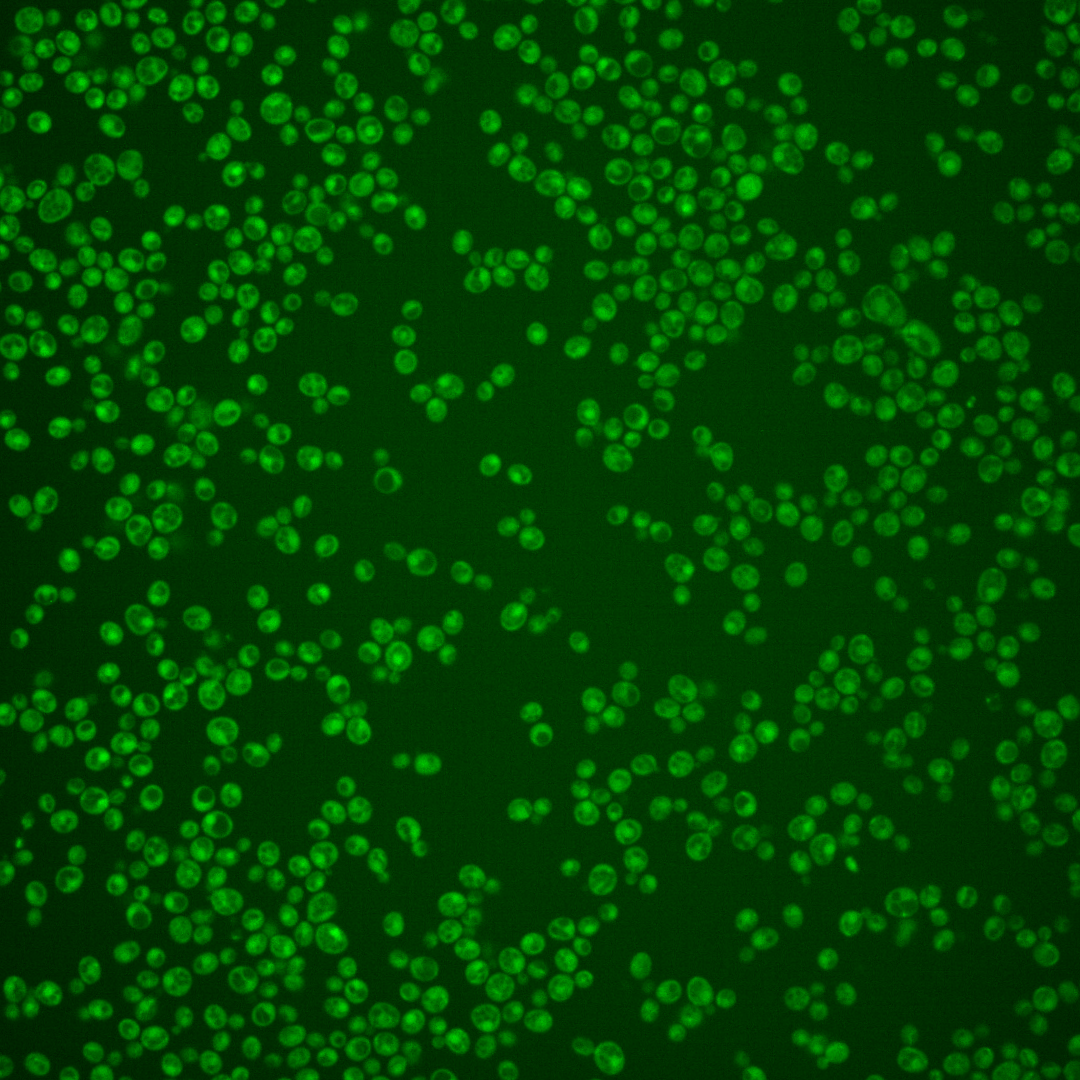

| Standard name | |
|---|---|
| Human Ortholog | |
| Description | Negative regulator of glucose-induced cAMP signaling; directly activates the GTPase activity of the heterotrimeric G protein alpha subunit Gpa2p |
Micrographs




















































































Sub-cellular Localization
Yeast GFP Assignment
Protein Abundance
Localization Change
External localization resources
| ensLOC | DeepLoc | |||||||||||||||||||||||
|---|---|---|---|---|---|---|---|---|---|---|---|---|---|---|---|---|---|---|---|---|---|---|---|---|
| Localization | WT1 | WT2 | WT3 | RAP60 | RAP140 | RAP220 | RAP300 | RAP380 | RAP460 | RAP540 | RAP620 | RAP700 | HU80 | HU120 | HU160 | rpd3Δ_1 | rpd3Δ_2 | rpd3Δ_3 | WT1 | WT2 | WT3 | AF100 | AF140 | AF180 |
| Cortical Patches | 0 | 1 | 0 | 1 | 0 | 0 | 0 | 0 | 0 | 0 | 0 | 0 | 0 | 0 | 0 | – | – | 0 | 4 | 7 | 5 | 1 | 5 | 3 |
| Bud | 0 | 0 | 1 | 1 | 2 | 0 | 1 | 1 | 8 | 5 | 4 | 10 | 0 | 0 | 0 | – | – | 0 | 0 | 3 | 3 | 1 | 4 | 3 |
| Bud Neck | 1 | 2 | 4 | 4 | 1 | 14 | 20 | 11 | 4 | 4 | 2 | 5 | 1 | 2 | 0 | – | – | 0 | 1 | 3 | 2 | 0 | 1 | 1 |
| Bud Site | 0 | 0 | 0 | 0 | 0 | 0 | 0 | 0 | 2 | 0 | 0 | 0 | 0 | 0 | 0 | – | – | 0 | – | – | – | – | – | – |
| Cell Periphery | 1 | 5 | 2 | 2 | 0 | 0 | 0 | 1 | 3 | 1 | 1 | 1 | 0 | 2 | 1 | – | – | 1 | 1 | 4 | 4 | 1 | 2 | 1 |
| Cytoplasm | 348 | 512 | 239 | 165 | 107 | 275 | 300 | 293 | 291 | 268 | 194 | 195 | 282 | 283 | 294 | – | – | 218 | 308 | 430 | 155 | 257 | 241 | 318 |
| Endoplasmic Reticulum | 1 | 5 | 1 | 0 | 1 | 0 | 1 | 0 | 0 | 0 | 0 | 0 | 0 | 0 | 0 | – | – | 12 | 0 | 2 | 4 | 0 | 1 | 0 |
| Endosome | 1 | 0 | 2 | 0 | 0 | 1 | 0 | 1 | 1 | 0 | 0 | 1 | 0 | 0 | 0 | – | – | 2 | 5 | 6 | 7 | 1 | 2 | 3 |
| Golgi | 0 | 1 | 1 | 0 | 0 | 0 | 0 | 0 | 0 | 0 | 0 | 0 | 0 | 0 | 1 | – | – | 0 | 0 | 1 | 3 | 0 | 3 | 0 |
| Mitochondria | 7 | 9 | 2 | 1 | 7 | 15 | 15 | 16 | 92 | 68 | 73 | 71 | 1 | 0 | 0 | – | – | 6 | 17 | 23 | 41 | 8 | 15 | 9 |
| Nucleus | 1 | 0 | 0 | 0 | 1 | 1 | 1 | 6 | 1 | 1 | 0 | 4 | 1 | 1 | 0 | – | – | 0 | 0 | 1 | 0 | 0 | 0 | 0 |
| Nuclear Periphery | 0 | 1 | 0 | 0 | 0 | 0 | 0 | 1 | 0 | 1 | 0 | 0 | 0 | 0 | 0 | – | – | 0 | 0 | 1 | 0 | 1 | 0 | 1 |
| Nucleolus | 0 | 0 | 1 | 1 | 0 | 0 | 0 | 3 | 1 | 0 | 0 | 1 | 1 | 0 | 0 | – | – | 0 | 0 | 0 | 0 | 0 | 0 | 1 |
| Peroxisomes | 0 | 1 | 1 | 0 | 0 | 0 | 1 | 0 | 0 | 0 | 0 | 1 | 0 | 0 | 0 | – | – | 0 | 1 | 1 | 0 | 0 | 0 | 0 |
| SpindlePole | 1 | 3 | 1 | 1 | 0 | 4 | 6 | 5 | 2 | 3 | 1 | 4 | 0 | 0 | 0 | – | – | 1 | 3 | 7 | 2 | 1 | 2 | 2 |
| Vac/Vac Membrane | 2 | 1 | 1 | 0 | 1 | 0 | 3 | 1 | 1 | 1 | 0 | 3 | 0 | 0 | 0 | – | – | 4 | 7 | 2 | 3 | 2 | 2 | 2 |
| Unique Cell Count | 355 | 529 | 247 | 168 | 113 | 288 | 312 | 316 | 338 | 316 | 236 | 250 | 284 | 283 | 295 | 222 | 359 | 509 | 258 | 285 | 294 | 361 | ||
| Labelled Cell Count | 363 | 541 | 256 | 176 | 120 | 310 | 348 | 339 | 406 | 352 | 275 | 296 | 286 | 288 | 296 | 244 | 359 | 509 | 258 | 285 | 294 | 361 | ||
Yeast GFP Assignment
Protein Abundance
| Screen | WT1 | WT2 | WT3 | RAP60 | RAP140 | RAP220 | RAP300 | RAP380 | RAP460 | RAP540 | RAP620 | RAP700 | HU80 | HU120 | HU160 | rpd3Δ_1 | rpd3Δ_2 | rpd3Δ_3 | AF100 | AF140 | AF180 |
|---|---|---|---|---|---|---|---|---|---|---|---|---|---|---|---|---|---|---|---|---|---|
| Mean Cell GFP Intensity (1e-4) | 3.9 | 3.6 | 5.0 | 4.4 | 3.8 | 4.1 | 4.1 | 4.6 | 3.3 | 3.7 | 3.3 | 3.5 | 4.4 | 4.6 | 4.4 | 4.0 | 4.8 | 4.9 | 4.7 | 4.9 | 5.0 |
| Std Deviation (1e-4) | 0.9 | 0.7 | 1.9 | 2.2 | 1.7 | 1.7 | 1.7 | 2.3 | 1.6 | 1.0 | 1.0 | 0.9 | 1.0 | 1.0 | 1.5 | 1.1 | 1.1 | 1.2 | 1.3 | 1.4 | 1.2 |
| Intensity Change (Log2) | – | – | – | -0.16 | -0.38 | -0.27 | -0.28 | -0.11 | -0.57 | -0.45 | -0.6 | -0.53 | -0.17 | -0.12 | -0.17 | -0.32 | -0.05 | -0.02 | -0.07 | -0.01 | 0.02 |
Localization Change
| Localization | RAP60 | RAP140 | RAP220 | RAP300 | RAP380 | RAP460 | RAP540 | RAP620 | RAP700 | HU80 | HU120 | HU160 | rpd3Δ_1 | rpd3Δ_2 | rpd3Δ_3 |
|---|---|---|---|---|---|---|---|---|---|---|---|---|---|---|---|
| Actin | – | – | – | – | – | – | – | – | – | – | – | – | – | – | – |
| Bud | – | – | – | – | – | – | – | – | – | – | – | – | – | – | – |
| Bud Neck | – | – | – | – | – | – | – | – | – | – | – | – | – | – | – |
| Bud Site | – | – | – | – | – | – | – | – | – | – | – | – | – | – | – |
| Cell Periphery | – | – | – | – | – | – | – | – | – | – | – | – | – | – | – |
| Cyto | – | – | – | – | – | – | – | – | – | – | – | – | – | – | – |
| Endoplasmic Reticulum | – | – | – | – | – | – | – | – | – | – | – | – | – | – | – |
| Endosome | – | – | – | – | – | – | – | – | – | – | – | – | – | – | – |
| Golgi | – | – | – | – | – | – | – | – | – | – | – | – | – | – | – |
| Mitochondria | – | – | – | – | – | – | – | – | – | – | – | – | – | – | – |
| Nuclear Periphery | – | – | – | – | – | – | – | – | – | – | – | – | – | – | – |
| Nuc | – | – | – | – | – | – | – | – | – | – | – | – | – | – | – |
| Nucleolus | – | – | – | – | – | – | – | – | – | – | – | – | – | – | – |
| Peroxisomes | – | – | – | – | – | – | – | – | – | – | – | – | – | – | – |
| SpindlePole | – | – | – | – | – | – | – | – | – | – | – | – | – | – | – |
| Vac | – | – | – | – | – | – | – | – | – | – | – | – | – | – | – |
| Cortical Patches | – | – | – | – | – | – | – | – | – | – | – | – | – | – | – |
| Cytoplasm | – | – | – | – | – | – | – | – | – | – | – | – | – | – | – |
| Nucleus | – | – | – | – | – | – | – | – | – | – | – | – | – | – | – |
| Vacuole | – | – | – | – | – | – | – | – | – | – | – | – | – | – | – |
External localization resources
Images






























Protein Concentration and Protein Localization Data
| R1 | R2 | R3 | ||||||||||||||||
|---|---|---|---|---|---|---|---|---|---|---|---|---|---|---|---|---|---|---|
| G1 Pre-START | G1 Post-START | S/G2 | Metaphase | Anaphase | Telophase | G1 Pre-START | G1 Post-START | S/G2 | Metaphase | Anaphase | Telophase | G1 Pre-START | G1 Post-START | S/G2 | Metaphase | Anaphase | Telophase | |
| Concentration | 2.1519 | 2.1495 | 2.0001 | 1.6513 | 2.2487 | 2.1789 | 4.9169 | 4.063 | 4.4601 | 5.2725 | 4.3954 | 4.6286 | 1.585 | 1.6185 | 1.6766 | 2.0083 | 1.4147 | 1.9379 |
| Actin | 0.0384 | 0.0001 | 0.016 | 0.0001 | 0.0249 | 0.0035 | 0.0483 | 0.0053 | 0.0217 | 0.0003 | 0.0039 | 0.0008 | 0.0224 | 0.0017 | 0.012 | 0.0157 | 0.0001 | 0.0087 |
| Bud | 0.0007 | 0.0001 | 0.0041 | 0 | 0.0002 | 0.0008 | 0.0055 | 0.0197 | 0.0078 | 0.0022 | 0.01 | 0.002 | 0.0023 | 0.0003 | 0.0014 | 0.0001 | 0.0005 | 0.0027 |
| Bud Neck | 0.0013 | 0 | 0.007 | 0 | 0.0002 | 0.0003 | 0.0009 | 0.0023 | 0.002 | 0.0001 | 0.0017 | 0.0031 | 0.0064 | 0.0001 | 0.0007 | 0.0001 | 0 | 0.0007 |
| Bud Periphery | 0.0024 | 0.0002 | 0.0043 | 0 | 0.0004 | 0.0035 | 0.0171 | 0.0235 | 0.0144 | 0.0046 | 0.0545 | 0.004 | 0.0083 | 0.0005 | 0.0033 | 0.0001 | 0.0011 | 0.0036 |
| Bud Site | 0.0037 | 0.0003 | 0.0169 | 0 | 0.0008 | 0.0001 | 0.0043 | 0.0242 | 0.0103 | 0.0001 | 0.0011 | 0.0013 | 0.0062 | 0.0024 | 0.0037 | 0.0004 | 0 | 0.0003 |
| Cell Periphery | 0.0011 | 0.0001 | 0.0003 | 0 | 0.0001 | 0.0002 | 0.0006 | 0.0006 | 0.0013 | 0.0002 | 0.0022 | 0.0002 | 0.0008 | 0.0003 | 0.0002 | 0 | 0 | 0.0001 |
| Cytoplasm | 0.0225 | 0.031 | 0.0232 | 0.029 | 0.0378 | 0.0367 | 0.0454 | 0.0259 | 0.0499 | 0.0312 | 0.0566 | 0.0516 | 0.0215 | 0.0262 | 0.0182 | 0.0132 | 0.028 | 0.0258 |
| Cytoplasmic Foci | 0.0076 | 0.0027 | 0.0064 | 0.0011 | 0.0166 | 0.0034 | 0.0129 | 0.002 | 0.0092 | 0.0075 | 0.0039 | 0.0074 | 0.0154 | 0.0041 | 0.0062 | 0.0089 | 0.003 | 0.0018 |
| Eisosomes | 0.0008 | 0.0003 | 0.0004 | 0.0001 | 0.0007 | 0.0002 | 0.0004 | 0.0002 | 0.0006 | 0.0001 | 0.0001 | 0.0001 | 0.0006 | 0.0004 | 0.0002 | 0.0001 | 0.0001 | 0.0002 |
| Endoplasmic Reticulum | 0.002 | 0.0003 | 0.001 | 0.0001 | 0.0011 | 0.0002 | 0.0059 | 0.0006 | 0.0042 | 0.0008 | 0.0024 | 0.0007 | 0.0021 | 0.0003 | 0.001 | 0.0002 | 0.0002 | 0.0003 |
| Endosome | 0.0081 | 0.0003 | 0.0036 | 0 | 0.0056 | 0.0003 | 0.0157 | 0.0002 | 0.0067 | 0.0014 | 0.0009 | 0.0007 | 0.0063 | 0.0002 | 0.0011 | 0.0027 | 0.0003 | 0.0005 |
| Golgi | 0.0031 | 0 | 0.0019 | 0 | 0.0036 | 0.0001 | 0.0076 | 0.0001 | 0.0028 | 0.0001 | 0.0002 | 0.0001 | 0.004 | 0.0002 | 0.001 | 0.004 | 0 | 0.0007 |
| Lipid Particles | 0.0144 | 0.0001 | 0.0026 | 0.0001 | 0.0185 | 0.0002 | 0.0037 | 0.0001 | 0.0013 | 0.0001 | 0.0006 | 0.0004 | 0.0047 | 0.0003 | 0.0039 | 0.0076 | 0.0001 | 0.0019 |
| Mitochondria | 0.0024 | 0.0002 | 0.002 | 0.0001 | 0.003 | 0.0005 | 0.004 | 0.0006 | 0.0016 | 0.0004 | 0.0011 | 0.0003 | 0.0031 | 0.0002 | 0.0012 | 0.0007 | 0.0004 | 0.0004 |
| None | 0.8674 | 0.9625 | 0.8845 | 0.9687 | 0.8384 | 0.9486 | 0.7886 | 0.8881 | 0.8439 | 0.9463 | 0.8448 | 0.9149 | 0.8629 | 0.9539 | 0.9291 | 0.9144 | 0.964 | 0.9459 |
| Nuclear Periphery | 0.0051 | 0.0001 | 0.0036 | 0.0001 | 0.0027 | 0.0002 | 0.0174 | 0.0007 | 0.0029 | 0.0013 | 0.0056 | 0.0013 | 0.0095 | 0.0002 | 0.0019 | 0.0007 | 0.0003 | 0.0004 |
| Nucleolus | 0.0014 | 0.0002 | 0.0013 | 0.0001 | 0.0007 | 0.0001 | 0.0005 | 0.0006 | 0.002 | 0.0002 | 0.0005 | 0.0006 | 0.0009 | 0.0002 | 0.0007 | 0.0001 | 0.0002 | 0.0004 |
| Nucleus | 0.003 | 0.0006 | 0.0058 | 0.0001 | 0.0007 | 0.0003 | 0.0037 | 0.0024 | 0.0047 | 0.0014 | 0.0022 | 0.0041 | 0.0038 | 0.0007 | 0.0024 | 0.0001 | 0.0004 | 0.0016 |
| Peroxisomes | 0.0082 | 0.0001 | 0.0086 | 0.0001 | 0.0298 | 0.0004 | 0.009 | 0.0002 | 0.0017 | 0.0001 | 0.0006 | 0.0003 | 0.0121 | 0.0067 | 0.0083 | 0.0274 | 0.0003 | 0.0019 |
| Punctate Nuclear | 0.0047 | 0.0004 | 0.0054 | 0.0002 | 0.0135 | 0.0003 | 0.003 | 0.0021 | 0.0093 | 0.0005 | 0.0046 | 0.0052 | 0.0028 | 0.0009 | 0.0025 | 0.0033 | 0.0007 | 0.0017 |
| Vacuole | 0.0013 | 0.0003 | 0.0006 | 0.0001 | 0.0005 | 0.0002 | 0.0029 | 0.0005 | 0.0014 | 0.0009 | 0.0017 | 0.0007 | 0.0026 | 0.0002 | 0.0009 | 0.0001 | 0.0002 | 0.0003 |
| Vacuole Periphery | 0.0004 | 0 | 0.0004 | 0 | 0.0003 | 0 | 0.0027 | 0.0001 | 0.0004 | 0.0003 | 0.0007 | 0.0002 | 0.0011 | 0 | 0.0004 | 0.0001 | 0.0001 | 0.0001 |
Sequencing Data
| R1 | R2 | |||||||||
|---|---|---|---|---|---|---|---|---|---|---|
| G1 Post-START | S/G2 | Metaphase | Anaphase | Telophase | G1 Post-START | S/G2 | Metaphase | Anaphase | Telophase | |
| Gene Expression | – | – | – | – | – | – | – | – | – | – |
| Translational Efficiency | – | – | – | – | – | – | – | – | – | – |
Hit Data
| Dataset | Hit |
|---|---|
| Protein Concentration | ✔ |
| Protein Localization | ✘ |
| Gene Expression | – |
| Translational Efficiency | – |
Endocytosis
| Temp | Actin Patch (Sac6-tdTomato) | Cortical Patch (Sla1-GFP) | Late Endosome (Snf7-GFP) | Vacuole (Vph1-GFP) |
|---|---|---|---|---|
| 37℃ | ||||
| RT |
Cell Cycle Omics
CYCLoPs (Rgs2-GFP)
| Gene / Allele | Actin Patch (Sac6-tdTomato) | Cortical Patch (Sla1-GFP) | Late Endosome (Snf7-GFP) | Vacuole (Sac6-tdTomato) |
|---|
| Gene | Images |
|---|
| Gene | Images |
|---|
Images are not yet available
Images are not yet available